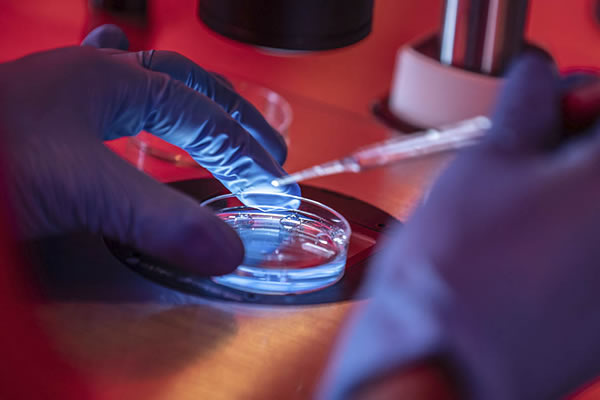

Question:
Dear Father Miguel Angel Fuentes,
My future husband and I attended one of the talks required by our diocese for all couples wishing to be married in the Church. These talks are mandatory.
While we were not entirely pleased with the content of the previous talks, the one we heard yesterday left us completely perplexed. The priest, speaking about artificial fertilization, stated that if the embryos are cared for and the doctors have a certain ethic, the Church permits fertilization outside the mother’s womb. I intervened, telling him that the Church does not agree with in vitro fertilization because it goes against natural law. Obviously, he cut me off and insisted that if it is done carefully, the Church permits it because its position has evolved with scientific progress.
Both my future husband and I are professionals, and for that reason, we were able to realize that there is something strange about these statements, but I don’t know what the other attendees will think.
Could you please tell me what the situation is regarding this topic? A priest friend of ours, whom we consulted, had me read ‘Donum Vitae’; we would like to know if there is anything more recent, since the priest’s argument is based on the idea that the Church has evolved over time.
Thank you very much in advance.
Answer:
Dear Madam,
What that priest affirmed about in vitro or ‘extra-corporeal’ fertilization has no magisterial foundation (if he was indeed referring to this procedure, which must not be confused with ‘assistance to procreation’ techniques: see the note I add at the end). Rather, it explicitly contradicts the Magisterium of the Church. The Instruction ‘Donum vitae’ (from the Sacred Congregation for the Doctrine of the Faith), which you already have according to your letter, is very clear on the matter and does not require new documents because its judgment is definitive on this point. This is why the said Instruction is not limited to analyzing techniques from the past or contemporary to it, but rather what in ethics is called a ‘simple case’. It literally states the following: ‘For the same reasons, the so-called “simple case,” that is, a homologous IVFET procedure free of any relation to the abortive practice of embryo destruction and to masturbation, remains a morally illicit technique, because it deprives human procreation of the dignity that is proper and inherent to it.’ The ‘simple case’ is the ideal case, which in fact has still not been scientifically achieved, in which all the ‘optimal’ conditions would be met: only gametes from the lawfully married spouses are used, there is no recourse to masturbation, only one egg is used to avoid multiple fertilizations, any abortive practice is discarded even if malformations are detected in the baby, there is no recourse to embryo freezing, etc. This case (which technology has not achieved, nor may it achieve in the more or less near future), remains ‘morally illicit’ because the essential moral problem persists: the dissociation of the unitive dimension (the normal conjugal act) and the procreative dimension, and the degradation of the dignity of the conceptus, upon which an act proper to technique is applied (the ‘making’; acts with which we treat material things) and not of morality (the ‘acting’: the only acts with which a human person is treated with dignity).
The same doctrine can be read in the Catechism of the Catholic Church n. 2377: ‘Techniques that involve only the married couple (homologous artificial insemination and fertilization) are perhaps less reprehensible, yet remain morally unacceptable.’
A statement of the same tenor, though less explained, is in the Encyclical Veritatis splendor, 47.
If that priest has any authoritative document of the Church in his favor that states the opposite of these texts, I would be extremely curious to know of it.
In Christ and Mary,
Fr. Miguel Ángel Fuentes, IVE
Note: Evidently, my judgment refers to in vitro fertilization, as you state in your email. I proceed on the basis that you understood the priest correctly and that he did not confuse the terms with the so-called ‘assistance to procreation,’ wrongly (or ambiguously) called ‘so-called improper artificial insemination’ (which Pius XII and the same Instruction Donum vitae already speak of as licit in some cases). Please see my article and the excellent article by Msgr. Caffarra on this matter.
Original Post: Here